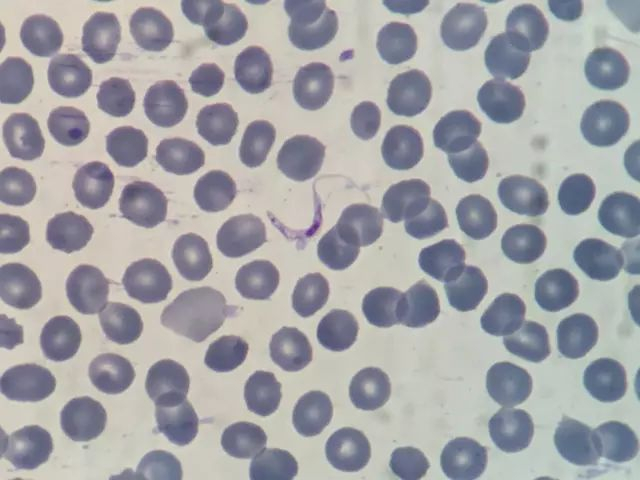

被非洲蝇咬了一口,福州黄依姐患上致命传染病,惊动世界卫生组织
东南快报

导读
福州41岁的黄依姐从非洲旅游回来后,
出现反复发烧、头晕、畏冷……
起初以为是感冒,
不料病情没有那么简单,
她患得是罕见感染性疾病,
甚至惊动了世界卫生组织(WHO)!!!

黄依姐感染了一种名叫“罗得西亚非洲锥虫病”,只见于非洲地区,在她之前中国没人得过。由采采蝇传播的寄生虫病,如果不及时对症治疗,一旦虫子进入脑部,将会致命。
连日来,经过福建医科大学附属协和医院、福建省疾病预防控制中心、上海华山医院、中国疾病预防控制中心寄生虫预防控制所等多方合作,WHO的特效药物争分夺秒从日内瓦空运至福州,黄依姐终于转危为安。
“起初不痛不痒,还以为只是普通苍蝇,没想到会得了这么严重的寄生虫病。”昨日,福州黄依姐说,7月22日至8月6日期间,她前往肯尼亚和坦桑尼亚等地旅游,度过了一个愉快的非洲之旅。
但刚回福州2天,黄依姐就莫名其妙地出现反复发热、头晕、畏冷、寒战等症状。以为是感冒,上医院开了药却没啥效果,于是8月10日她转到福建医科大学附属协和医院。


▲被采采蝇叮咬后,皮肤会出现“锥虫下疳”
协和感染科邹来玉主治医师和急诊科郑华副主任医师先后接诊。在详细询问病史的过程中,医生了解到黄依姐在非洲旅行途中曾不慎被昆虫叮咬,她的右脚后跟还有暗红色包块。
医生们意识到黄女士很可能得了一种罕见感染性疾病,目前造成体温不退,肝功能持续恶化,随时会有生命危险,立即予以收治入院。
紧接着,医生们将黄依姐血液标本送检省疾病预防控制中心,查找特殊病原体。
8月14日上午9时20分,省疾控中心检验人员从血样中检出非洲锥虫,同时将部分血样送往中国疾病预防中心寄生虫病预防控制所进行基因测定。
经中国疾病预防控制中心确认:黄依姐的标本中呈罗得西亚锥虫抗体阳性,她感染得是罗得西亚锥虫病。

▲网络配图:采采蝇
省疾控中心寄生虫病防治科谢汉国副主任技师说,非洲锥虫病主要流行于非洲中部、撒哈拉沙漠以南的36个国家,其中坦桑尼亚也有流行,每年都会发现近百例。其中布氏冈比亚锥虫引起冈比亚锥虫病,布氏罗得西亚锥虫引起罗得西亚锥虫病。这种非洲锥虫病的潜伏期约2周,病程可分为初期、血液期、睡眠期3期。
所幸黄依姐及早就医,病程正处在血液期。不过,一旦锥虫进入脑部,就会出现昏迷、嗜睡等症状,甚至可能出现猝死。
明确诊断只是第一步,接下来及时的治疗至关重要。这种病只见于非洲地区,国内的医院没有常备药物,所有药物均需世界卫生组织调配。一场争分夺秒地生死救援拉开序幕。

▲网络配图
8月14日13:30,中国疾控寄生虫病预防控制所牵头,世界卫生组织总部、世卫组织北京办事处、省疾控中心及福建协和医院感染科共同成立锥虫病救治团队(HCT小组),并召开了电话会议。WHO在会议上确认了该病例,并准许拨发药物。
根据黄依姐的锥虫虫种和病程,首选药物为苏拉明,在苏拉明未到药时,能做的只有等待吗?HCT小组的成员想到可以先使用喷他脒。
很快,中国疾控、世卫组织、省疾控中心及福建协和医院感染科等13人组成了“HCT应急组微信群”,通过互联网+,打破空间限制寻找“救命药”。


当晚,好消息传来:香港有喷他脒!省疾控中心立刻协调医生开具证明、病情介绍和处方,患者亲友到香港购买药物喷他脒带回。
同时,协和医院急诊科主任刘青、陈小玲医生认真研究药物英文说明书,查阅文献,并与香港药师、世界卫生组织专家、中国疾控专家沟通联系,沟通注意事项及相关经验。
8月15日22:41,用最快速度带回国的喷他脒,通过静脉输液缓缓进入黄女士体内。
从8月14日13:30到15日22:41,历时30多个小时的生死救援,虽然黄依姐肝功能没有好转,但她居高不下的体温终于有所下降了。
8月16日,特效药——苏拉明也到了。由专人携带坐飞机从日内瓦直飞北京,再由患者家属从北京带回福州。

此次,世界卫生组织开通国际救援“绿色通道”,同时经中国疾控寄研所和省疾控中心专家协调努力,调拨特效药物苏拉明,从日内瓦到福建协和医院感染科病房,路上仅花了一天时间。而以往通过邮件、海关手续至少要花十天,这为成功抢救争取到宝贵的时间。
8月18日16:58,特效药物苏拉明测试剂量缓缓泵入黄依姐体内。
接着经过三次特效药物治疗,8月25日,黄依姐体温及肝功能均恢复正常后就出院了。
目前,黄依姐还在协和医院定期随访,继续用特效药治疗。昨日,她做了第五次治疗,还剩下最后一次,预计9月14日左右可以结束。
昨日,省疾控中心副主任张山鹰介绍,此次我省发现的是全国首例输入性罗得西亚锥虫病确诊病例,同时也是中国第二例输入性非洲锥虫病病例。2014年中国确诊首例输入性非洲锥虫病病例属于冈比亚锥虫病。
不过,国内没有采采蝇这种传播媒介,因此,输入性锥虫病例不会造成本地传播和扩散。
张山鹰提醒,一旦在非期间或回国后身体出现不适,应立即就医,并主动向医生讲明自己曾到过非洲什么地方以及被什么蚊虫叮咬过,以便医生诊断。如果医务人员有接诊境外输入的不明原因发热,可以及时与疾控部门联系,共同寻找病因。

▲网络配图
另外,援非工作人员、赴非务工人员和游客,旅行前应咨询各地出入境检疫局等机构,了解热带病知识,同时要注意做好防范“功课”,包括:旅行时尽量坐车并关好车窗;在户外活动时,身体裸露部位涂抹蚊虫驱避剂;避免赴高危区域,慎入森林、牧场、草地、灌木丛等吸血昆虫孳生地,如必须进入这些环境,应穿长衣长裤长袜,尽量不穿黑色或蓝色等吸引蚊虫的深色衣服;避免在简陋居所睡觉,夜晚睡眠要使用蚊帐或在室内喷洒杀虫剂;不轻易到河塘中游泳、戏水,避免接触不熟悉的水体;注意饮食卫生,不喝生水,不食用可能受蚊蝇污染的食物、饮料,不食用半生不熟的食物等。
东快记者 林雅 通讯员 杨大文/文 医生供图 编辑:钟文兴

